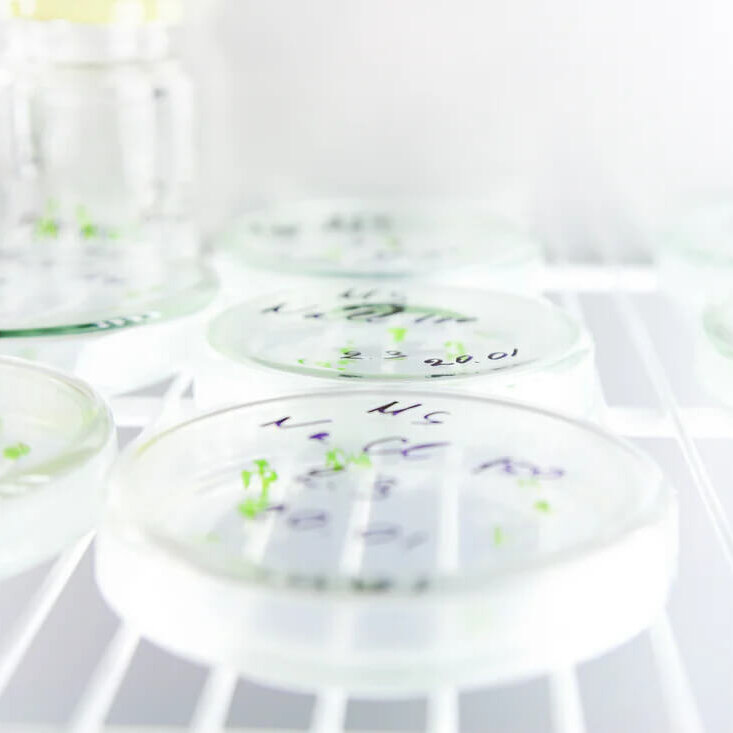
Suspension Culture Technology

Fermentation Foam Control: Principles, Causes, and Solutions
Foam is a common issue in industrial fermentation, and if not properly controlled, it can disrupt the entire process. Understanding how foam forms, what problems it can cause, and how to manage it is essential for smooth and efficient fermentation.